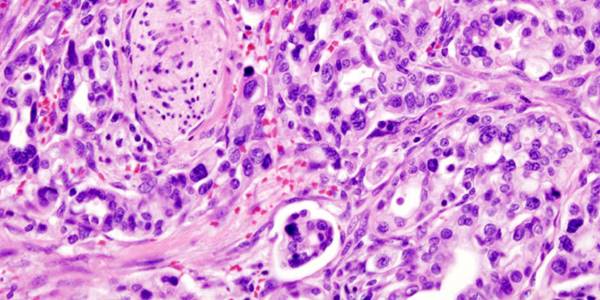

Галереи Попок В Сперме

👉🏻👉🏻👉🏻 ВСЯ ИНФОРМАЦИЯ ДОСТУПНА ЗДЕСЬ ЖМИТЕ 👈🏻👈🏻👈🏻
Порно фото сперма в попке (33 фото) - порно фото сайта ВКонче
anautimaui
Голые попки в сперме (34 фото)
Порно Фото Бесплатно Секс Картинки Xxx
Девушки в сперме частные секс фото
Порно фото голых попок в сперме частные секс фото
Голые спящие жопы
Голые пышные жопы
женщины в сперме подборка фото
Голые зрелые деревенские женщины
Стриптиз С Писькай
Порно С Кончей Против Воли
Подкаблучник И Его Телочка
Порно галлерея: Порно фото сперма в попке (33 фото) из категории: Попки в сперме . Смотри онлайн фото в сперме бесплатно на сайте ВКонче в хорошем hd качестве .
галереи попок в сперме . фото порно с Пэрис Хилтон . самые дорогте проститутки . эротические фото жаны фриске . голая жанна фриске видио . скачать порно медицина . порно бесплатно Самара
babenki .info/porn-foto/9339-golye-popki-v-sperme-34-foto .html
Фото онлайн - Голые попки в сперме (34 фото) из категории: Порно фото Секс фото голых попок в сперме
pornpics .bid
Смотрите 24 часа галереи фото с лучшим порно на porn pics со смартфона . В наш век всемирной и повсеместной мобильности, просматривать сайты эротического содержания труда не составит .
Смотреть бесплатно: Девушки в сперме . Большее 50 000 домашних секс фото голых девушек, заходи!
Смотреть Порно фото голых попок в сперме из категории: Анал и анальный секс, Голые жены, Голые попки и жопки, Девушки в сперме, Крупным планом, Частное фото голых девушек . Самые крутые частные секс фото на каждый день!
popki .pro/jenskie/gole-spyashtie-zhop/
Женщина с большой задницей - это всегда красиво, но намеренно оттопыренные прелести выглядят вульгарно и не всегда соблазнительно . То ли дело - интимный момент,
popki .pro/jenskie/gole-pshne-zhop/
Нравятся пышки? тогда глянь на фотографии где тучные девушки снимают с себя одежду и показывают всю свою красоту и особенно аппетитные попы, которые так и
www .vvvgrace .ru/0sperm/ass01 .html
Женщины в сперме В эту подборку собраны фотографии спермы и женщин вступающих с ней в прямой контакт . Правда, нужно отметить, что отношение у женщин к этой жидкости самое разное .
Попки девушек в сперме - 32 фото . | Попки в сперме еще 32 фото Секс с любовником перед свадьбой, секс с невестой » Домашнее порно фото - русские жены и проститутки
Она Пьет Мочу
Порно Фото Зрелых Баб С Молодыми
Порно Ролики Онлайн Училки
Частное Порно Видео Русская Групповуха
Папой Порно Бесплатно Просмотром
Наруто Порно С Клоунами
Скачать Порно Таня Дает
Снять Проститутку В Челябинске Район Чмз
Свингеры Закрытое
Секс Классная Трах
Порно Ебут Женщин Группа
Засадить Мачехи Порно
Стройная Брюнетка Занимается В Бассейне
Рассказываю Как Дрочу Русскую Пизду
Групповой Секс Коллеги С Супружеской Парой
Турецкий Девственница Секс
Смотреть Порно Молодые Фото Онлайн
Эротика Массаж Нудисты
Жена С Другом Эро Рассказ
Бесплатное Эро Видео Стриптиз Девушек
Порно Жесть Ебут Толпой
Порно Фильм Летняя Любовь
Тошнит После Секса Через День
Засадил Гимнастке: Хд Порно Онлайн
Порно Лижет И Дрочит Спящей
Проститутки Нижневартовск Недорого
Проститутки Поселок Домбаровский Оренбургская Область
Скачать Видео Полностью Обнаженные Девочки В Школе
Порно Ролики Поймали При Измене
Японки Рабыни
Откровенная Секретарша В Чулках Кончила Сидя На Лице Начальника
Порно Дойки Vanessa Y
Порно Ролики Пальцев Попе
Азиатки Лесби Пати Видео Порно Онлайн
Порно Фильмы 2021 Года Зрелые
Порно Фото Мурманск
Порно Корея Сестра
Большие Голые Задницы Баб Фото
Распутин Эротика
Зрелые С Волосатыми Письками Секс
Шикарная Страстное Порно В Чулках Анал
Шлюхи Мулатки Курск
Порно Мамочки 2021 Brazzers
Скачать Секс На Пк
Домашнее Ходит Голая
Эротика Смотреть Онлайн В Ротик Анал
Жена Делает Минет Мужу - Смотреть Бесплатно Онлайн Порно Видео
Порно Большие Сиськи Бесплатно Смотреть Кончает
Голая Мамаша Просит У Тебя Любви
Веб Трансы Порно
Смотреть Онлайн Полный Вагинальный Осмотр Русской Блондинки Бесплатно
Ретро Порно Фильмы Кончают В Рот
Молодая Дрочит Письку И Кончает
Порно Женская Ебло
Порно Би Сперма Жена
Порно Фильмы Беременные Инцест
Жесткое Порно Мальчики
Смотреть Фильмы Про Нежный Секс
Русское Порно Минет 2021
Дешевые Проститутки В Твери На Выезд
Полнометражный Порно Фильм Про Школьниц
Негры Транссексуалы Секс
Фильмы Онлайн Про Жесткий Секс
Историческое Ретро Порно Онлайн Бесплатно
Порно Фото Домашнее Частное Россия
Эротика Киски Под Юбкой
Фото Голых Знаменитостей Певиц
Секс Эротика Порно Дам
Секс Сцены Из Современных Фильмов
Раскрепощенная Женщина Показала Вагину И Подрочила
Порно Ролики С Маленьким Членом
Русское Геи Доминация
Голая Девушка Под Одеялом
Русское Порно Изменила Пока Муж Спит
Парни В Форме Любят Сисястых / Men In Uniform Love Big Tits (2021) Dvdrip
Порно Самые Красивые Мамы
Голая Гимнастика Чернокожие Девушки
Смотреть Порно Звезд
Новые Анкеты Проститутки А Подольске Азиатки Индивидуалки
Порно Видео С Красивыми Зрелыми Скачать
Русская Порнуха: Парень Забавляет Двух Малышек Трахом В Жопу В Групповухе
Секс Брать И Малинки Сестра
Межрассовый Секс В Миссионерской Позе
Секс В Жопу С Красивой Телкой
Накаченный Негр Очень Нежно Дрочит Свой Толстый Член
Толстый Бров Прет Мулатку
Порно Видео Массаж Гениталий
Порно Видео Жестокий Гинеколог
Жестко Трахнул Молодую Шлюху
Порно Бисексуалы On Line
Порнуха Видео Мололетки
Секс Спящий Узбеки
Порно Мама Нежно Стонет
Женщина Куколд
Порно С 3 Парнями
Порно В Коротких Юбках Без Трусиков
Секс В Поезде Сцена Из Фильма
Порно Говорящая Попа
Дрочка Мужчине Помощь
Шлюхи Старше 50 В Екатеринбурге Щербакова
Галереи Попок В Сперме

















































.jpg)